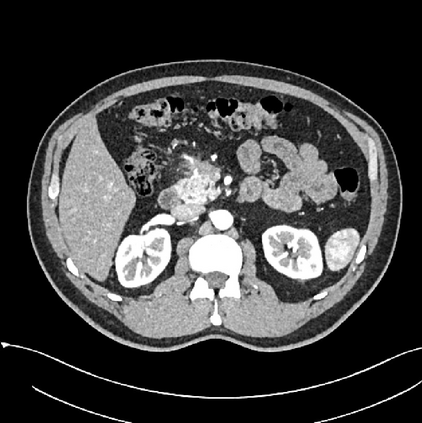

Early tumor detection save lives. Each year, more than 300 million computed tomography (CT) scans are performed worldwide, offering a vast opportunity for effective cancer screening. However, detecting small or early-stage tumors on these CT scans remains challenging, even for experts. Artificial intelligence (AI) models can assist by highlighting suspicious regions, but training such models typically requires extensive tumor masks--detailed, voxel-wise outlines of tumors manually drawn by radiologists. Drawing these masks is costly, requiring years of effort and millions of dollars. In contrast, nearly every CT scan in clinical practice is already accompanied by medical reports describing the tumor's size, number, appearance, and sometimes, pathology results--information that is rich, abundant, and often underutilized for AI training. We introduce R-Super, which trains AI to segment tumors that match their descriptions in medical reports. This approach scales AI training with large collections of readily available medical reports, substantially reducing the need for manually drawn tumor masks. When trained on 101,654 reports, AI models achieved performance comparable to those trained on 723 masks. Combining reports and masks further improved sensitivity by +13% and specificity by +8%, surpassing radiologists in detecting five of the seven tumor types. Notably, R-Super enabled segmentation of tumors in the spleen, gallbladder, prostate, bladder, uterus, and esophagus, for which no public masks or AI models previously existed. This study challenges the long-held belief that large-scale, labor-intensive tumor mask creation is indispensable, establishing a scalable and accessible path toward early detection across diverse tumor types. We plan to release our trained models, code, and dataset at https://github.com/MrGiovanni/R-Super
翻译:暂无翻译